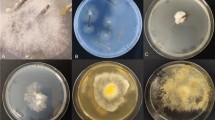

Abstract
THE methods previously adopted for the insect transmission of the viruses causing swollen-shoot disease of cacao (Theobroma cacao L.) employed seedlings usually between six and twelve months old. An improved technique utilizes the seed as a test plant and a watch-glass or specimen tube as a cage, a method which might be applicable to experiments with viruses of other plants with exalbuminous seeds.
This is a preview of subscription content, access via your institution
Access options
Subscribe to this journal
Receive 51 print issues and online access
$199.00 per year
only $3.90 per issue
Buy this article
- Purchase on SpringerLink
- Instant access to the full article PDF.
USD 39.95
Prices may be subject to local taxes which are calculated during checkout
Similar content being viewed by others
Author information
Authors and Affiliations
Rights and permissions
About this article
Cite this article
POSNETTE, A. Use of Seeds in the Insect Transmission of Some Plant Viruses. Nature 159, 500–501 (1947). https://doi.org/10.1038/159500b0
Issue date:
DOI: https://doi.org/10.1038/159500b0